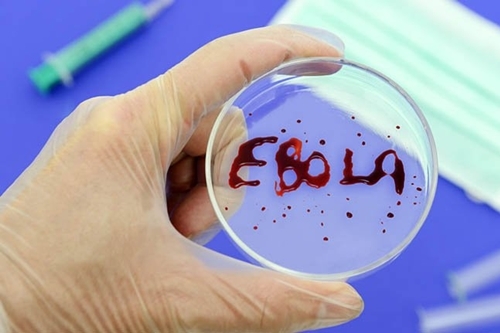
Virus sốt Ebola đã lây lan đến Châu Á

Du khách bị trục xuất khỏi Đài Loan vì mang theo thứ đồ này
Lén mang hộp cơm có thịt heo quay khi nhập cảnh vào Đài Loan (Trung Quốc), vị khách Indonesia đã bị phạt 6.200 USD nhưng không đủ tiền trả nên bị trục xuất.

Lén mang hộp cơm có thịt heo quay khi nhập cảnh vào Đài Loan (Trung Quốc), vị khách Indonesia đã bị phạt 6.200 USD nhưng không đủ tiền trả nên bị trục xuất.

Trong bối cảnh làn sóng Omicron bắt đầu "hạ nhiệt", nhiều nước châu Âu đã nới lỏng các quy định kiểm dịch đối với du khách quốc tế.

Vì không đeo khẩu trang nên bị chặn lại ở chố kiểm soát dịch bệnh ở xã Tiên Minh (Hải Phòng), nam thanh niên đã lấy dao chém cán bộ trực chốt.
Đà Nẵng sẽ dừng các chốt kiểm soát dịch COVID-19 ra vào cửa ngõ TP bắt đầu từ 12h hôm nay.

Trong ngày 20/11, số ca mắc COVID-19 tại Đà Nẵng tăng cao, với 44 trường hợp dương tính SARS-CoV-2, trong đó có 10 ca cộng đồng.

Sau cuộc nhậu, Y Hải Ayun (33 tuổi, ở Đắk Lắk) chửi bới, yêu cầu lực lượng chức năng gỡ phong toả rồi vác rìu đuổi chém cán bộ công an.

Qua kiểm tra, lực lượng chức năng phát hiện, ngoài 2 người ngồi trong cabin còn có 7 người khác trốn trong thùng xe được phủ kín, xếp đầy vât tư xây dựng.

Để vượt chốt kiểm soát dịch bệnh vào địa phận tỉnh Quảng Ninh, Linh đã thuê một người đàn ông chèo thuyền vượt sông.

Không được cho qua chốt kiểm dịch vì ra đường không đúng quy định, các đối tượng bất ngờ dùng dao tấn công lực lượng làm nhiệm vụ tại chốt.
Bộ Công an đã phối hợp với Công an TP.HCM tổ chức lắp đặt 100 camera đọc mã QR tại các chốt kiểm soát dịch COVID-19.

Nguyễn Văn Bắc bị khởi tố về hành vi "Chống người thi hành công vụ" tại chốt kiểm soát dịch COVID-19 trên địa bàn huyện Nông Cống, tỉnh Thanh Hóa.

Trường hợp nam thanh niên vượt rào chốt Covid để thăm bạn gái và có hành vi chém công an, luật sư cho rằng, phải phạt tù mới đủ sức răn đe.

UBND quận Hải Châu, Đà Nẵng ra quyết định xử phạt hành chính 2 thanh niên từ khu vực "vùng xanh" thông chốt kiểm soát dịch để đi mua rượu.

Dù cố tránh né nhưng nam nhân viên kiểm dịch vẫn bị người phụ nữ đánh trúng rồi ngã xuống đất.

Mặc dù đi tử TP.HCM về nhưng tại chốt kiểm dịch COVID-19, người phụ nữ không đeo khẩu trang, không chấp hành khai báo y tế, thậm chí còn chống đối lực lượng chức năng.

Lực lượng chức năng tại chốt kiểm soát phòng, chống dịch COVID-19 tại cầu Vàng Chua liên tiếp phát hiện các trường hợp trốn khai báo y tế hoặc khai báo gian dối để vào Quảng Ninh.

Không chỉ trốn chốt kiểm dịch COVID-19, khi bị lực lượng chức năng yêu cầu dừng xe, Hậu đã lớn tiếng đe dọa đồng thời hành hung chiến sĩ công an.

Lực lượng chức năng vừa tiến hành bắt giữ hai đối tượng có hành vi vận chuyển trái phép chất ma túy trên cao tốc Hạ Long – Hải Phòng.

Ông Lưu Văn Thanh bị bãi nhiệm chức Phó Chủ tịch HĐND huyện Hớn Quản do chống đối, không chịu đo thân nhiệt tại chốt kiểm dịch Covid-19.

Do mâu thuẫn tình cảm, Đô đã dùng búa đập vào đầu người yêu rồi đi xe máy đến chốt kiểm dịch để tự thú.

Do có hành vi giật khẩu trang, tát vào mặt và đe dọa thành viên tổ kiểm soát dịch Covid-19, một người phụ nữ đã bị TAND quận Ngô Quyền tuyên phạt 6 tháng tù.

Công an huyện Nông Sơn đã khởi tố vụ án, khởi tố bị can đối với Nguyễn Văn Phương về hành vi "Chống người thi hành công vụ".

Ngày 27/2 vừa qua, tại sân bay quốc tế ở Đài Loan, một nữ du khách Việt bị từ chối nhập cảnh khi bị phát hiện định mang theo chế phẩm từ thịt lợn chưa kiểm dịch.
(ĐSPL) - Dự báo thời tiết hôm nay 2/9: Mưa mở rộng từ các tỉnh Bắc Bộ xuống các tỉnh thành Bắc Trung Bộ. Ở khu vực phía Nam, ngày nắng nhiều, chiều tối có mưa.
(ĐSPL) - Qua loạt đạn vang lên liên hồi lúc rạng sáng, người đàn ông và thiếu phụ tử vong trên vũng máu ở gác xép.

(ĐSPL) - Đây là loài mọt nguy hiểm thuộc danh mục đối tượng kiểm dịch thực vật của Việt Nam và chưa có trên lãnh thổ nước ta.

(ĐSPL) - Ngày 23/10, Công an huyện Quỳnh Lưu (Nghệ An) cho biết, đơn vị vừa bắt giữ chiếc xe ô tô khách chở gần 3.000 con gia cầm không rõ nguồn gốc.

(ĐSPL) - 8 cá thể động vật quý hiếm vừa được Trung tâm Cứu hộ, bảo tồn và Phát triển sinh vật, Ban quản lý vườn quốc gia Phong Nha – Kẻ Bàng (Quảng Bình) thả về rừng.
(ĐSPL) - Hôm 17/8, một phụ nữ bay từ Nigeria đến Ấn Độ đã chết trong khu vực quá cảnh của sân bay Abu Dhabi.

Khô bò đen thành phần không thể thiếu cho món bánh tráng trộn nhưng ít ai ngờ chúng lại được làm từ phổi heo và chế biến trong điều kiện rất mất vệ sinh.